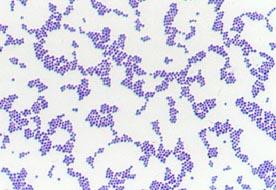

- •Http://vetfac.Nsau.Edu.Ru
- •Препараты живых микроорганизмов
- •Дифференциально-диагностические среды
- •Комбинированные дифференциально-диагностические среды (варианты 3-х сахарного агара)
- •Плотные элективные, дифференциально-диагностические среды для энтеробактерий
- •Обогатительные (накопительные) среды
- •Транспортные среды
- •Возбудители анаэробных инфекций
- •Биопроба при анаэробных инфекциях
- •Среды для выявления и дифференциации энтеробактерий при санитарно-микробиологических исследованиях
- •Лептоспироз
- •Кампилобактериоз
Препараты живых микроорганизмов
А Б
Б В
В
А.Препарат «раздавленная капля», культура Sarcina sp.
Б. Препарат «раздавленная капля», культура лептоспир (тёмнопольная микроскопия)
В. Препарат «раздавленная капля», культура микрококков, прижизненная окраска по методу Наканиши (метиленовым синим).
Окраска бактерий простыми методами
А Б
Б А.Спирохеты
(Borellia
sp.)в
патологическом материале, окраска
генцианвиолетом. Б. Культура
возбудителя ботулизма (Clostridium
botulinum),
окраска фуксином Циля.
А.Спирохеты
(Borellia
sp.)в
патологическом материале, окраска
генцианвиолетом. Б. Культура
возбудителя ботулизма (Clostridium
botulinum),
окраска фуксином Циля.
Окраска бактерий сложными методами.
Окраска по Граму:
А Б
Б
В Г
Г .
А.Золотистый стафилококк (Staphylococcus
aureus)
– Грамположителен. Б. Синегнойная
палочка (Pseudomonas
aeruginosa)
– Грамотрицательна. В. Clostridium
perfringens
– молодые микробные клетки грамположительны,
старые микробные клетки грамотрицательны.
Г. Актиномицет (Аctinomycetes)
– Грамположителен.
.
А.Золотистый стафилококк (Staphylococcus
aureus)
– Грамположителен. Б. Синегнойная
палочка (Pseudomonas
aeruginosa)
– Грамотрицательна. В. Clostridium
perfringens
– молодые микробные клетки грамположительны,
старые микробные клетки грамотрицательны.
Г. Актиномицет (Аctinomycetes)
– Грамположителен.
Окраска кислото-щелоче-спиртоустойчивых микроорганизмов по Цилю-Нильсену
 Возбудитель
туберкулёза (Mycobacterium
tuberculosis)
окрашивается по Цилю-Нильсону в красный
цвет, фон препарата – голубой.
Возбудитель
туберкулёза (Mycobacterium
tuberculosis)
окрашивается по Цилю-Нильсону в красный
цвет, фон препарата – голубой.
Окраска возбудителя туберкулёза аурамином (МФ)
 Возбудитель
туберкулёза (Mycobacterium
tuberculosis)
окрашивается аурамином в золотистый
цвет, фон препарата – зеленый.
Возбудитель
туберкулёза (Mycobacterium
tuberculosis)
окрашивается аурамином в золотистый
цвет, фон препарата – зеленый.
Окраска бруцелл по Козловскому
 Бруцеллы (Brucella
melitensis)
в мазке из патологического материала
окрашиваются по Козловскому в красный
цвет, остальная микрофлора и клетки
ткани – в зеленый или синий цвет.
Бруцеллы (Brucella
melitensis)
в мазке из патологического материала
окрашиваются по Козловскому в красный
цвет, остальная микрофлора и клетки
ткани – в зеленый или синий цвет.
Окраска на выявление биполярности микроорганизмов
А
А. Pasteurella multocida в мазке из крови. Окраска по Михину (метиленовым синим);
Б
Б. Yersinia pestis в мазке из патологического материала. Окраска по Романовскому-Гимза.
Капсулы бактерий
А Б
Б В
В
А.Bacillus anthracis, окраска по Романовскому-Гимзе. Б.Bacillus anthracis, окраска по Михину. В.Klebsiella pneumonia, окраска по Бурри-Гинсу
Споры бактерий
А Б
Б
В Г
Г

А. Clostridium tetani, окраска по Граму (вегетативные клетки тёмно-фиолетовые, споры не прокрашиваются);
Б. Cl.chauvoei в патологическом материале, окраска по Романовскому-Гимза (споры не прокрашиваются);
В. Bacillus anhtracis, окраска по Трухильо (вегетативные клетки красные, споры – зелёные);
Г. Bacillus anhtracis, окраска по Мюллеру(вегетативные клетки синие, споры –красные);
.
КУЛЬТИВИРОВАНИЕ МИКРООРГАНИЗМОВ


Колонии микроорганизмов на плотной питательной среде


Посев по Дригальскому (на сектора плотной питательной среды). Цель посева – получение изолированных колоний.

КЛАССИФИКАЦИЯ ПИТАТЕЛЬНЫХ СРЕД
Простые питательные среды:
А. Мясо-пептонный бульон - МПБ (слева – рост синегнойной палочки на МПБ), Б. мясо-пептонный агар – МПА (рост листерий на МПА); В. мясо-пептонная желатина – МПЖ (рост возбудителя сибирской язвы на МПЖ).
А Б
Б
 В
В
Специальные питательные среды:
Г.Кровяной агар - обогащенная питательная среда для многих видов патогенных микроорганизмов, среда для определения гемолитических свойств микроорганизмов. Питательная основа- Мясо-пептонный агар; Дифференцирующее вещество - кровь (эритроциты); индикатора нет.
Д.Сахарный бульон – обогащённая питательная среда для стрептококков и других требовательных микроорганизмов. Питательная основа - мясо-пептонный бульон;
Г .
. Д.
Д.
Специальные среды по особой рецептуре
А. Сахарно-кровяной агар Цейслера для анаэробов;
Б. Среда Петраньяни для возбудителей туберкулёза;
А. Б.
Б.
Элективные, дифференциально-диагностические среды
Желточно-солевой агар – предназначен для выделения чистой культуры стафилококков с подавлением роста сопутствующих микроорганизмов. Вырастающие стафилококки дифференцируются по наличию лецитовителазы. Питательная основа - мясо-пептонный агар, элективный фактор - 10% Na Cl, Дифференцирующее вещество - лецитин куриного яйца. Индикатора нет.
Среда Плоскирева – предназначена для выделения патогенных энтеробактерий (Shigella spp., Salmonella spp.) и подавления роста E.coli. Поскольку рост сопутствующей флоры подавляется не полностью, вырастающие эшерихии отличают по способности расщеплять лактозу. Питательная основа - мясо-пептонный агар; элективный фактор - соли желчных кислот; дифференцирующее вещество – лактоза. Индикатор - феноловый красный.


